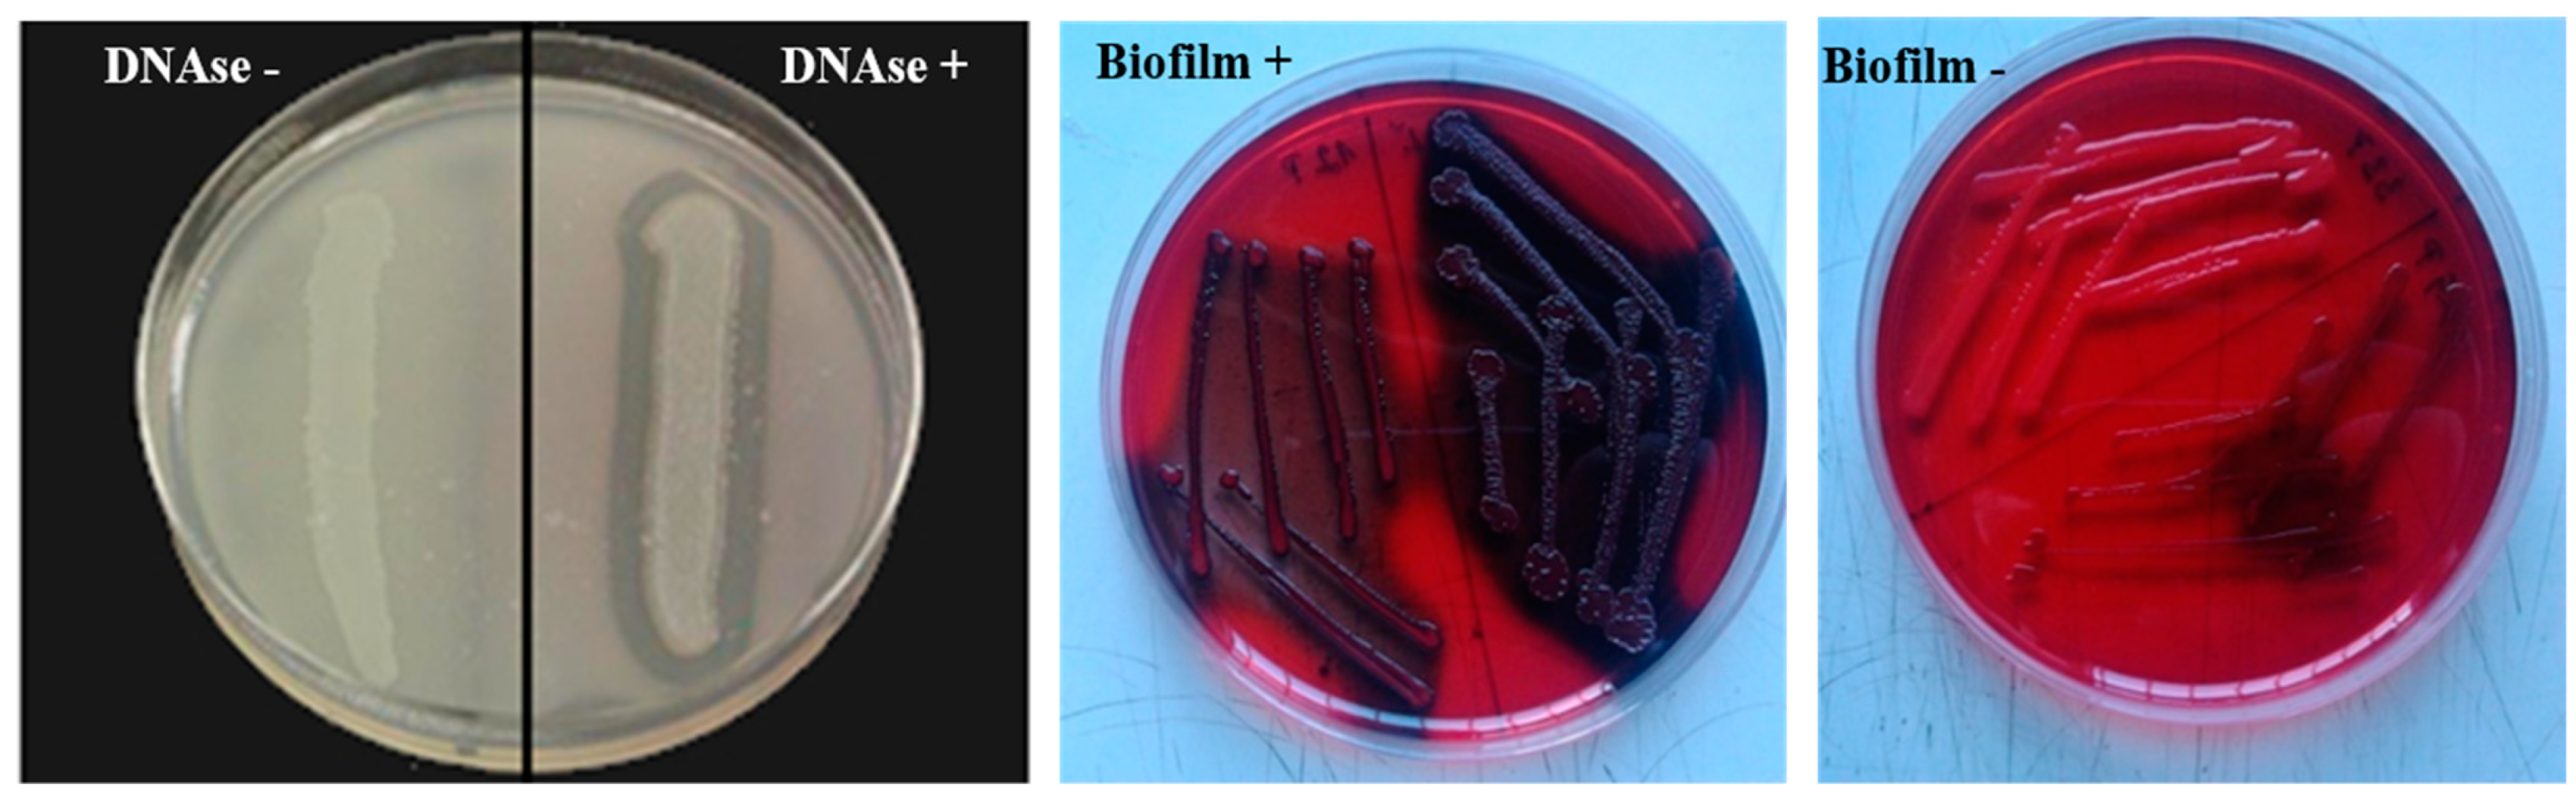
Animals 12 00470 g001 Animals 12 00470 g001

Dairy Cows’ Udder Pathogens and Occurrence of Virulence Factors in Staphylococci
Abstract
Simple Summary
Abstract
1. Introduction
2. Materials and Methods
2.1. Monitored Dairy Farms
2.2. Dairy Cow Selection and Udder Health Examination
2.3. Cultivation and Determination of Bacterial Pathogens
2.4. DNase Test and Detection of Biofilm and Hemolysis in Staphylococci
2.5. Detection of Sensitivity to Antimicrobials in Staphylococci
Detection of the mecA Gene from Isolated Staphylococci
2.6. Statistical Analysis
3. Results
4. Discussion
5. Conclusions
Supplementary Materials
Author Contributions
Funding
Institutional Review Board Statement
Informed Consent Statement
Data Availability Statement
Acknowledgments
Conflicts of Interest
References
- Augère-Granier, M.L. The EU Dairy Sector: Main Features, Challenges and Prospects. Briefing EU. 2018, p. 12. Available online: https://www.europarl.europa.eu/thinktank/en/document/EPRS_BRI(2018)630345 (accessed on 17 December 2018).
- Tančin, V.; Mikláš, Š.; Čobirka, M.; Uhrinčať, M.; Mačuhová, L. Factors affecting raw milk quality of dairy cows under practical conditions. Potravin. Slovak J. Food Sci. 2020, 14, 744–749. [Google Scholar] [CrossRef]
- Cobirka, M.; Tančin, V.; Slama, P. Epidemiology and Classification of Mastitis. Animals 2020, 10, 2212. [Google Scholar] [CrossRef] [PubMed]
- Dufour, S.; Labrie, J.; Jacques, M. The Mastitis Pathogens Culture Collection. Microbiol. Resour. Announc. 2019, 8, e00133-19. [Google Scholar] [CrossRef] [PubMed]
- Zigo, F.; Vasil’, M.; Ondrašovičová, S.; Výrostková, J.; Bujok, J.; Pecka-Kielb, E. Maintaining Optimal Mammary Gland Health and Prevention of Mastitis. Front. Vet. Sci. 2021, 8, 607311. [Google Scholar] [CrossRef] [PubMed]
- Zigo, F.; Farkašová, Z.; Lacková, Z.; Výrostková, J.; Regecová, I.; Vargová, M.; Sasáková, N. Occurrence of some pathogenity factors in Staphylococci isolated from mastitic dairy cows. In Food Safety and Food Quality (Slovak); Proceedings of the Scientific Papers; SPU: Nitra, Slovakia, 2021; pp. 190–196. [Google Scholar] [CrossRef]
- Singha, S.; Koop, G.; Persson, Y.; Hossain, D.; Scanlon, L.; Derks, M.; Hoque, M.A.; Rahman, M.M. Incidence, Etiology, and Risk Factors of Clinical Mastitis in Dairy Cows under Semi-Tropical Circumstances in Chattogram, Bangladesh. Animals 2021, 11, 2255. [Google Scholar] [CrossRef] [PubMed]
- Monistero, V.; Graber, H.U.; Pollera, C.; Cremonesi, P.; Castiglioni, B.; Bottini, E.; Ceballos-Marquez, A.; Lasso-Rojas, L.; Kroemker, V.; Wente, N.; et al. Staphylococcus aureus Isolates from Bovine Mastitis in Eight Countries: Genotypes, Detection of Genes Encoding Different Toxins and Other Virulence Genes. Toxins 2018, 10, 247. [Google Scholar] [CrossRef] [PubMed]
- Condas, L.A.Z.; De Buck, J.; Nobrega, D.B.; Domonique, A.C.; Roy, J.P.; Greg, P.K.; De Vries, T.J.; Middleton, J.R.; Dufour, S.; Barkema, H.W. Distribution of non-aureus staphylococci species in udder quarters with low and high somatic cell count, and clinical mastitis. J. Dairy Sci. 2017, 100, 5613–5627. [Google Scholar] [CrossRef]
- El-Diasty, M.; Talaat, H.; Atwa, S.; Elbaz, E.; Eissa, M. Occurrence of Coagulase-negative Staphylococcal mastitis in dairy cows. Mansoura Vet. Med. J. 2019, 23, 35–39. [Google Scholar] [CrossRef]
- Ferroni, L.; Lovito, C.; Scoccia, E.; Dalmonte, G.; Sargenti, M.; Pezzotti, G.; Maresca, C.; Forte, C.; Magistrali, C.F. Antibiotic Consumption on Dairy and Beef Cattle Farms of Central Italy Based on Paper Registers. Antibiotics 2020, 9, 273. [Google Scholar] [CrossRef]
- Holko, I.; Tančin, V.; Vršková, M.; Tvarožková, K. Prevalence and antimicrobial susceptibility of udder pathogens isolated from dairy cows in Slovakia. J. Dairy Res. 2019, 86, 436–439. [Google Scholar] [CrossRef]
- Idriss, S.E.; Foltys, V.; Tančin, V.; Kirchnerová, K.; Zaujec, K. Mastitis pathogens in milk of dairy cows in Slovakia. Slovak J. Anim. Sci. 2013, 46, 115–119. [Google Scholar]
- Nascimento, J.S.; Fugundes, P.C.; Brito, A.V.; Dos Santos, K.R.; Bastos, M.C. Production of bacteriocins by coagulase-negative staphylococci involved in bovine mastitis. Vet. Microbiol. 2005, 106, 61–71. [Google Scholar] [CrossRef]
- De Buck, J.; Ha, V.; Naushad, S.; Nobrega, D.B.; Luby, C.; Middleton, J.R.; De Vliegher, S.; Barkema, H.W. Non-aureus Staphylococci and Bovine Udder Health: Current Understanding and Knowledge Gaps. Front. Vet. Sci. 2021, 8, 658031. [Google Scholar] [CrossRef] [PubMed]
- Fergestad, M.E.; Visscher, A.; De L’Abee-Lund, T.; Ngassam Tchamba, C.; Mainil, J.G.; Thiry, D.; De Vliegher, S.; Wasteson, Y. Antimicrobial resistance and virulence characteristics in 3 collections of staphylococci from bovine milk samples. J. Dairy Sci. 2021, 104, 10250–10267. [Google Scholar] [CrossRef] [PubMed]
- Grinberg, A.; Hittman, A.; Leyland, M.; Rogers, L.; Le Quesne, B. Epidemiological and molecular evidence of a monophyletic infection with Staphylococcus aureus causing a purulent dermatitis in a dairy farmer and multiple cases of mastitis in his cows. Epidemiol. Infect. 2004, 132, 507–513. [Google Scholar] [CrossRef] [PubMed]
- Vasiľ, M.; Elečko, J.; Zigo, F.; Farkašová, Z. Occurrence of some pathogenity factors in coagulase negative staphylococci isolated from mastitis milk in dairy cows. Potravin. Slovak J. Food Sci. 2012, 6, 60–63. [Google Scholar] [CrossRef]
- Regecová, I.; Výrostková, J.; Zigo, F.; Gregová, G.; Kováčová, M. Detection of Antimicrobial Resistance of Bacteria Staphylococcus chromogenes Isolated from Sheep’s Milk and Cheese. Antibiotics 2021, 10, 570. [Google Scholar] [CrossRef]
- Haveri, M.; Roslöf, A.; Pyörälä, S. Virulence genes of bovine Staphylococcus aureus from persistent and nonpersistent intramammary infections with different clinical characteristics. J. Appl. Microbiol. 2007, 103, 993–1000. [Google Scholar] [CrossRef]
- National Research Council (NRC). Nutrient Requirements of Dairy Cattle: Seventh Revised Edition; The National Academies Press: Washington, DC, USA, 2001; p. 405. ISBN 978-0-309-38815-3. [Google Scholar] [CrossRef]
- Tančin, V. Somatic cell counts in milk of dairy cows under practical conditions. Slovak J. Anim. Sci. 2013, 46, 31–34. [Google Scholar] [CrossRef][Green Version]
- Adkins, P.R.F.; Middleton, J.R.; Fox, L.K.; Pighetti, G.; Petersson-Wolfe, C. Laboratory Handbook on Bovine Mastitis; National Mastitis Council: New Prague, MN, USA, 2017; p. 148. ISBN 978-0-309-06997-7. [Google Scholar]
- Gregova, G.; Kmet, V. Antibiotic resistance and virulence of Escherichia coli strains isolated from animal rendering plant. Sci. Rep. 2020, 10, 17108. [Google Scholar] [CrossRef]
- El-Aziz, A.N.K.; Ammar, A.M.; El Damaty, H.M.; Abd Elkader, R.A.; Saad, H.A.; El-Kazzaz, W.; Khalifa, E. Environmental Streptococcus uberis Associated with Clinical Mastitis in Dairy Cows: Virulence Traits, Antimicrobial and Biocide Resistance, and Epidemiological Typing. Animals 2021, 11, 1849. [Google Scholar] [CrossRef] [PubMed]
- Hiko, A. DNase-cross-Coagulase test and antimicrobial resistance test on Staphylococcus along beef abattoir line in Addis Ababa Ethiopia. Ethiop. Vet. J. 2019, 23, 90–110. [Google Scholar] [CrossRef]
- Vasil’, M.; Farkasova, Z.; Elecko, J.; Illek, J.; Zigo, F. Comparison of biofilm formation by Staphylococcus aureus and Staphylococcus epidermidis strains isolated from sheep milk using three diagnostic methods. Pol. J. Vet. Sci. 2017, 20, 795–801. [Google Scholar] [CrossRef] [PubMed]
- Moraveji, Z.; Tabatabaei, M.; Shirzad Aski, H.; Khoshbakht, R. Characterization of hemolysins of Staphylococcus strains isolated from human and bovine, southern Iran. Iran. J. Vet. Res. 2014, 15, 326–330. [Google Scholar]
- CLSI Document M2–A13; Performance Standards for Antimicrobial Disk Susceptibility Tests, Thirteenth Informational Supplement. Clinical and Laboratory Standards Institute: Wayne, PA, USA, 2018.
- CLSI Document M100–S31; Performance Standards for Antimicrobial Susceptibility Testing, Thirty–First Informational Supplement. Clinical and Laboratory Standards Institute: Wayne, PA, USA, 2021.
- Hein, I.; Jorgensen, H.J.; Loncarevic, S.; Wagner, M. Quantification of Staphylococcus aureus in unpasteurised bovine and caprine milk by real-time PCR. Res. Microbiol. 2005, 156, 554–563. [Google Scholar] [CrossRef]
- Poulsen, A.B.; Skov, R.; Pallesen, L.V. Detection of methicillin resistance in coagulase-negative staphylococci and in staphylococci directly from simulated blood cultures using the EVIGENE MRSA Detection Kit. J. Antimicrob. Chemother. 2003, 51, 419–421. [Google Scholar] [CrossRef]
- Nitz, J.; Wente, N.; Zhang, Y.; Klocke, D.; tho Seeth, M.; Krömker, V. Dry Period or Early Lactation—Time of Onset and Associated Risk Factors for Intramammary Infections in Dairy Cows. Pathogens 2021, 10, 224. [Google Scholar] [CrossRef]
- Persson Waller, K.; Bengtsson, B.; Lindberg, A.; Nyman, A.; Ericsson Unnerstad, H. Incidence of mastitis and bacterial findings at clinical mastitis in Swedish primiparous cows-influence of breed and stage of lactation. Vet. Microbiol. 2009, 134, 89–94. [Google Scholar] [CrossRef]
- Silva, A.C.; Laven, R.; Benites, N.R. Risk Factors Associated with Mastitis in Smallholder Dairy Farms in Southeast Brazil. Animals 2021, 11, 2089. [Google Scholar] [CrossRef]
- Rahman, M.; Bhuiyan, M.; Kamal, M.; Shamsuddin, M. Prevalence and risk factors of mastitis in dairy cows. Bangladesh Vet. 2010, 26, 54–60. [Google Scholar] [CrossRef]
- Wenz, J.R.; Barrington, G.M.; Garry, F.B. Bacteremia associated with naturally occuring acute coliform mastitis in dairy cows. J. Am. Vet. Med. Assoc. 2001, 219, 976–981. [Google Scholar] [CrossRef] [PubMed]
- Pyörälä, S.; Taponen, S. Coagulase-negative staphylococci—Emerging mastitis pathogens. Vet. Microbiol. 2009, 134, 3–8. [Google Scholar] [CrossRef] [PubMed]
- Zigo, F.; Elecko, J.; Vasil, M.; Ondrasovicova, S.; Farkasova, Z.; Malova, J.; Takac, L.; Zigova, M.; Bujok, J.; Pecka-Kielb, E.; et al. The occurrence of mastitis and its effect on the milk malondialdehyde concentrations and blood enzymatic antioxidants in dairy cows. Vet. Med. 2019, 64, 423–432. [Google Scholar] [CrossRef]
- Supre, K.; Haesebrouck, F.; Zadoks, R.N.; Vaneechoutte, M.; Piepers, S.; De Vliegher, S. Some coagulase-negative Staphylococcus species affect udder health more than others. J. Dairy Sci. 2011, 94, 2329–2340. [Google Scholar] [CrossRef] [PubMed]
- Hosseinzadeh, S.; Saei, H.D. Staphylococcal species associated with bovine mastitis in the North West of Iran: Emerging of coagulase-negative staphylococci. Int. J. Vet. Sci. Med. 2014, 2, 27–34. [Google Scholar] [CrossRef]
- Fredheim, E.G.A.; Klingenberg, C.; Rodhe, H.; Frankenberger, S.; Gaustad, P.; Flaegstad, T.; Sollid, J.E. Biofilm formation by Staphylococcus haemolyticus. J. Clin. Microbiol. 2009, 47, 1172–1180. [Google Scholar] [CrossRef]
- Pérez, V.K.C.; Da Costa, G.M.; Sá Guimarães, A.; Heinemann, M.B.; Lage, A.P.; Dorneles, E.M.S. Relationship between virulence factors and antimicrobial resistance in Staphylococcus aureus from bovine mastitis. J. Glob. Antimicrob. Res. 2020, 22, 792–802. [Google Scholar] [CrossRef]
- Melchior, M.B.; Van Osch, M.H.J.; Lam, T.J.G.M.; Vernooij, J.C.M.; Gaastra, W.; Fink-Gremmels, J. Extended biofilm susceptibility assay for Staphylococcus aureus bovine mastitis isolates: Evidence for association between genetic makeup and biofilm susceptibility. J. Dairy Sci. 2011, 94, 5926–5937. [Google Scholar] [CrossRef]
- Khazandi, M.; Al-Farha, A.A.B.; Coombs, G.W.; O’Dea, M.; Pang, S.; Trott, D.J.; Aviles, R.R.; Hemmatzadeh, F.; Venter, H.; Ogunniyi, A.D.; et al. Genomic characterization of coagulase-negative staphylococci including methicillin-resistant Staphylococcus sciuri causing bovine mastitis. Vet. Microbiol. 2021, 219, 17–22. [Google Scholar] [CrossRef]
- Vyleťelova, M.; Vlkova, H.; Manga, I. Occurrence and Characteristics of Methicillin Resistant Staphylococcus aureus and Methicillin Resistant Coagulase-negative Staphylococci in Raw Milk Manufacturing. Czech. J. Food Sci 2011, 29, 11–16. [Google Scholar] [CrossRef]
- Bogdanovičová, K.; Skočková, A.; Šťástková, Z.; Karpíšková, R. Occurrence and antimicrobial resistance of Staphylococcus aureus in bulk tank milk and milk filters. Potravin. Slovak J. Food Sci. 2014, 8, 97–101. [Google Scholar] [CrossRef]
- Seixas, R.; Santos, J.P.; Bexiga, R.; Vilela, C.L.; Oliveira, M. Short communication: Antimicrobial resistance and virulence characterization of methicillin-resistant staphylococci isolates from bovine mastitis cases in Portugal. J. Dairy Sci. 2014, 97, 340–344. [Google Scholar] [CrossRef] [PubMed]
- Corti, S.; Sicher, D.; Regli, W.; Stephan, R. Current data on antibiotic resistance of the most important bovine mastitis pathogens in Switzerland. Schweiz Arch. Tierheilkd. 2003, 145, 571–575. [Google Scholar] [CrossRef] [PubMed]
- Vinodkumar, K.; Neetha, N.; Ashok, S.; Suchithra, S.; Justin, D.; Radhik, S. Genotypic and phenotypic β-lactam resistance and presence of PVL gene in Staphylococci from dry bovine udder. PLoS ONE 2017, 12, e0187277. [Google Scholar] [CrossRef]
- Bardiau, M.K.; Yamazaki, J.N.; Duprez, B.; Taminiau, J.; Mainil, G.; Ote, I. Genotypic and phenotypic characterization of methicillin-resistant Staphylococcus aureus (MRSA) isolated from milk of bovine mastitis. Lett. Appl. Microbiol. 2013, 57, 181–186. [Google Scholar] [CrossRef]
- Vanderhaeghen, W.; Cerpentier, T.; Adriaensen, C.; Vicca, J.; Hermans, K.; Butaye, P. Methicillin-resistant Staphylococcus aureus (MRSA) ST398 associated with clinical and subclinical mastitis in Belgian cows. Vet. Microbiol. 2010, 144, 166–171. [Google Scholar] [CrossRef]
- EU. European Union’s Farm to Fork Strategy—For a Fair, Healthy and Environmentally-Friendly Food System; EU: Brussels, Belgium, 2020; p. 13. Available online: https://ec.europa.eu/food/sites/food/files/safety/docs/f2f_action-plan_2020_strategy-info_en.pdf (accessed on 17 June 2020).

| Pathogens | Number of Isolates | % (n = 230) | Clinical IMI 1 n/% | Chronic IMI 2 | Subclinical IMI 3 n/% | ||
|---|---|---|---|---|---|---|---|
| CM1 | CM2 | CM3 | n/% | ||||
| NAS | 98 | 42.6 | 28/12.2 | 7/3.0 | 2/1.3 | 8/3.5 | 53/23.0 |
| S. aureus | 38 | 16.5 | 10/4.3 | 5/2.2 | 3/1.3 | 11/4.7 | 9/3.9 |
| Escherichia coli | 26 | 11.2 | 5/2.2 | 2/0.9 | 0/0 | 2/0.9 | 17/7.4 |
| Streptococcus uberis | 21 | 9.1 | 4/1.7 | 4/1.7 | 1/0.4 | 7/3.0 | 5/2.2 |
| Streptococcus agalactiae | 8 | 3.4 | 0/0 | 3/1.3 | 0/0 | 3/1.3 | 2/0.9 |
| Streptococcus spp. | 10 | 4.3 | 4/1.7 | 0/0 | 0/0 | 0/0 | 6/2.6 |
| Enterococcus spp. | 14 | 6.1 | 2/0.9 | 1/0.4 | 0/0 | 0/0 | 11/4.8 |
| Mixed infection 4 | 15 | 6.5 | 4/1.7 | 2/0.9 | 0/0 | 4/1.7 | 5/2.2 |
| Total | 230 | 100 | 57/24.7 | 24/10.5 | 6/2.6 | 35/15.2 | 108/46.9 |
| Staphylococcus spp./Number | IMI 1/Number | Hemolysins 2 | DNAse 3 | Gelatinase | Biofilm | mecA Gene | Testing Value |
|---|---|---|---|---|---|---|---|
| S. aureus (38) | clinical (18) | 6α/4δ/1β | 14 | 15 | 9 | 2 | 5.447 * |
| chronic (11) | 3α/2δ/2β | 8 | 7 | 7 | 0 | ||
| subclinical (9) | 3α/1β | 6 | 7 | 5 | 0 | ||
| S. chromogenes (22) | clinical (11) | 4β/3δ | 3 | 4 | 4 | 0 | 3.204 * |
| chronic (4) | 3β | 1 | 1 | 2 | 1 | ||
| subclinical (7) | 2β/2δ | 1 | 1 | 2 | 0 | ||
| S. warneri (20) | clinical (9) | 4δ/2β | 2 | 2 | 4 | 1 | 2.688 * |
| chronic (3) | 3β | 0 | 0 | 1 | 0 | ||
| subclinical (8) | 3β/1δ | 2 | 0 | 2 | 0 | ||
| S. xylosus (18) | clinical (7) | 2δ/2β | 2 | 0 | 3 | 0 | 2.255 * |
| chronic (1) | 0 | 0 | 0 | 0 | 0 | ||
| subclinical (10) | 4β/1δ | 0 | 0 | 2 | 0 | ||
| S. epidermidis (9) | clinical (2) | 1δ | 0 | 0 | 1 | 0 | 1.012 |
| subclinical (7) | 2δ | 0 | 0 | 2 | 0 | ||
| S. haemolyticus (7) | clinical (4) | 2β/1δ | 1 | 0 | 2 | 0 | 0.742 |
| subclinical (3) | 0 | 0 | 0 | 0 | 0 | ||
| S. capitis (6) | clinical (2) | 2δ | 0 | 0 | 0 | 0 | 0.401 |
| subclinical (4) | 0 | 0 | 0 | 0 | 0 | ||
| S. piscifermentans (6) | clinical (2) | 1β | 0 | 0 | 1 | 0 | 0.851 |
| subclinical (4) | 2δ | 0 | 0 | 0 | 0 | ||
| S. hyicus (10) | clinical (0) | 0 | 0 | 0 | 0 | 0 | 0.332 |
| subclinical (10) | 1δ | 0 | 0 | 1 | 0 |
| Bacterial Strains (n = 136) | S. aureus (n = 38) | S. chromogenes (n = 22) | S. warneri (n = 20) | S. xylosus (n = 18) | Other NAS * (n = 39) | |||||
|---|---|---|---|---|---|---|---|---|---|---|
| Antibiotic/Resistance | % | n | % | n | % | n | % | n | % | n |
| Penicillin | 18.4 | 7 | 13.6 | 3 | 20.0 | 4 | 11.1 | 2 | 10.3 | 4 |
| Amoxicillin | 18.4 | 7 | 18.1 | 4 | 15.0 | 3 | 11.1 | 2 | 10.3 | 4 |
| Ampicillin | 23.6 | 9 | 18.1 | 4 | 20.0 | 4 | 16.7 | 3 | 15.4 | 6 |
| Amox. + clav. | 0 | 0 | 0 | 0 | 0 | 0 | 0 | 0 | 0 | 0 |
| Oxacillin | 13.2 | 5 | 13.6 | 3 | 15.0 | 3 | 11.1 | 2 | 5.1 | 2 |
| Cefoxitin | 10.5 | 4 | 9.0 | 2 | 10.0 | 2 | 0 | 0 | 0 | 0 |
| Cephalexin | 10.5 | 4 | 9.0 | 2 | 0 | 0 | 0 | 0 | 0 | 0 |
| Ciprofloxacin | 10.5 | 4 | 9.0 | 2 | 10.0 | 2 | 11.1 | 2 | 0 | 0 |
| Lincomycin | 13.2 | 5 | 9.0 | 2 | 5.0 | 1 | 11.1 | 2 | 7.7 | 3 |
| Neomycin | 29.0 | 11 | 18.1 | 4 | 20.0 | 4 | 16.7 | 3 | 15.4 | 6 |
| Novobiocin | 18.4 | 7 | 18.1 | 4 | 10.0 | 2 | 77.8 | 14 | 7.7 | 3 |
| Rifaximin | 5.3 | 2 | 0 | 0 | 0 | 0 | 0 | 0 | 0 | 0 |
| Streptomycin | 29.0 | 11 | 27.3 | 6 | 25.0 | 5 | 11.1 | 2 | 17.9 | 7 |
| Tetracycline | 5.3 | 2 | 0 | 0 | 0 | 0 | 0 | 0 | 0 | 0 |
| Number Group of Antimicrobials | Phenotypic Resistance Profile | Number of Isolates | % of Isolates |
|---|---|---|---|
| 0 | 30 | 22.1 | |
| 1 | STR | 11 | 8.1 |
| 1 | PEN | 9 | 6.6 |
| 1 | NMC | 8 | 5.9 |
| 1 | AMX | 7 | 5.1 |
| 1 | NVB | 6 | 4.4 |
| 1 | AMP | 6 | 4.4 |
| 1 | LNC | 4 | 2.9 |
| 2 | NMC, STR | 9 | 6.6 |
| 2 | AMP, NVB | 4 | 2.9 |
| 2 | CPR, NVB | 2 | 2.2 |
| 2 | LNC, NVB | 2 | 1.5 |
| 3 | PEN, AMX, OXA | 4 | 2.9 |
| 3 | AMP, AMX, OXA | 3 | 2.2 |
| 3 | PEN, LNC, NVB | 2 | 1.5 |
| 3 | AMP, OXA, NMC | 3 | 2.2 |
| 3 | AMP, AMX, NVB | 4 | 2.9 |
| 3 | PEN, AMX, AMC, | 2 | 1.5 |
| 3 * | NVB, LNC, STR | 4 | 2.9 |
| 4 | AMP, CEP, FOX, OXA | 3 | 2.2 |
| 4 * | RFX, CPR, STR, TET | 2 | 1.5 |
| 4 * | CPR, LNC, NMC, NVB | 3 | 2.2 |
| 4 * | NVB, CPR, NMC, STR | 2 | 1.5 |
| 4 * | AMP, CEP, FOX, PEN | 3 | 2.2 |
| 5 * | OXA, FOX, AMP, NMC, STR | 2 | 1.5 |
| Total ATBs resistant isolates | 105 | 77.2 | |
Publisher’s Note: MDPI stays neutral with regard to jurisdictional claims in published maps and institutional affiliations. |
© 2022 by the authors. Licensee MDPI, Basel, Switzerland. This article is an open access article distributed under the terms and conditions of the Creative Commons Attribution (CC BY) license (https://creativecommons.org/licenses/by/4.0/).
Share and Cite
Zigo, F.; Farkašová, Z.; Výrostková, J.; Regecová, I.; Ondrašovičová, S.; Vargová, M.; Sasáková, N.; Pecka-Kielb, E.; Bursová, Š.; Kiss, D.S. Dairy Cows’ Udder Pathogens and Occurrence of Virulence Factors in Staphylococci. Animals 2022, 12, 470. https://doi.org/10.3390/ani12040470
Zigo F, Farkašová Z, Výrostková J, Regecová I, Ondrašovičová S, Vargová M, Sasáková N, Pecka-Kielb E, Bursová Š, Kiss DS. Dairy Cows’ Udder Pathogens and Occurrence of Virulence Factors in Staphylococci. Animals. 2022; 12(4):470. https://doi.org/10.3390/ani12040470
Chicago/Turabian StyleZigo, František, Zuzana Farkašová, Jana Výrostková, Ivana Regecová, Silvia Ondrašovičová, Mária Vargová, Naďa Sasáková, Ewa Pecka-Kielb, Šárka Bursová, and David Sandor Kiss. 2022. "Dairy Cows’ Udder Pathogens and Occurrence of Virulence Factors in Staphylococci" Animals 12, no. 4: 470. https://doi.org/10.3390/ani12040470
APA StyleZigo, F., Farkašová, Z., Výrostková, J., Regecová, I., Ondrašovičová, S., Vargová, M., Sasáková, N., Pecka-Kielb, E., Bursová, Š., & Kiss, D. S. (2022). Dairy Cows’ Udder Pathogens and Occurrence of Virulence Factors in Staphylococci. Animals, 12(4), 470. https://doi.org/10.3390/ani12040470

